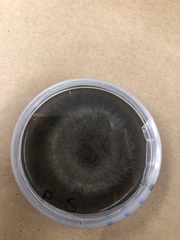
Phialocephala

Phialocephala: taxon details and analytics
- Domain
- Kingdom
- Fungi
- Phylum
- Ascomycota
- Class
- Leotiomycetes
- Order
- Helotiales
- Family
- Mollisiaceae
- Genus
- Phialocephala
- Species
- Scientific Name
- Phialocephala
Summary description from Wikipedia:
Phialocephala
Phialocephala is a genus of fungi in the family Mollisiaceae. It has a worldwide distribution. It contains 39 accepted species and numerous undescribed taxa.
...Images from inaturalist.org observations:
We recommend you sign up for this excellent, free service.